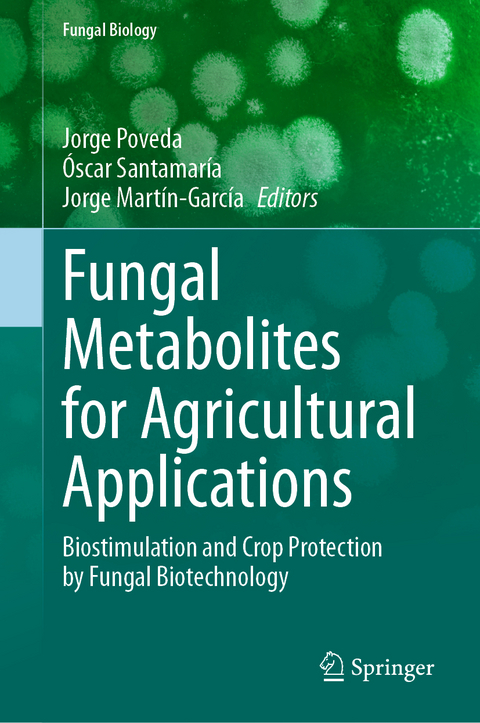
Fungal Metabolites for Agricultural Applications -

Fungal Metabolites for Agricultural Applications
Springer International Publishing (Verlag)
978-3-031-76586-5 (ISBN)
This book delves into the fascinating world of fungal metabolites and their biotechnological potential for sustainable agriculture. Through this book, readers will learn about the production and characterization of metabolites by endophytic and rhizospheric fungi, including filamentous fungi like Trichoderma, Penicillium, and Aspergillus, as well as mycorrhizal fungi and yeasts.
The chapters cover topics such as the promotion of plant growth, increased tolerance to abiotic stresses, and biological control through the application of fungal metabolites. Expert contributors provide an in-depth analysis of how these metabolites can be produced in bioreactors or applied directly as agricultural bioinoculants. Particular attention is given to the environmental and health benefits of using fungal metabolites in crop improvement.
Researchers in the field of agricultural biotechnology, plant sciences, and environmental sustainability will find this book invaluable. It offers a comprehensive discussion from biological, chemical, and applied perspectives, making it a must-read for anyone interested in advancing sustainable agriculture practices.
Prof. Dr. Dr. Jorge Poveda works as a Professor in Genetics and Biotechnology at the Department of Plant Production and Forest Resources of University of Valladolid, Spain. He has a PhD in Agrobiotechnology and a PhD in Biosystems Engineering. He has extensive experience in the study of plant-endophyte fungal interaction, with numerous articles and reviews published in the last five years (Scopus: 62 papers). Regarding specifically the Trichoderma fungus, he has published articles that are referenced in the study of the Trichoderma-plant interaction, besides several highly cited reviews. In addition to endophytes and rhizospheric-endophytes fungi (such as Trichoderma), he has worked on their agricultural application with mycorrhizal fungi. In recent years, his research has addressed the relationship between plant and beneficial fungi from other approaches, such as metabolomics. In this sense, he has published several papers on the role of plant metabolites in plant-fungus symbiosis and on the production of metabolites of agricultural biotechnological interest by Trichoderma and even pathogenic fungi, such as Leptosphaeria maculans (with beneficial plant applications).
Prof. Dr. Óscar Santamaría works as a Professor in Agronomy and Forestry at the Department of Plant Production and Forest Resources of University of Valladolid, Spain. He is a Forest Engineer (PhD in Forest Pathology) with an interest in fungal endophytes and how they can be used as biocontrol agents against plant diseases or as plant growth promoting organisms in their hosts through the secondary metabolites they produce. Within this area, he has been involved as a researcher in more than 20 research projects, acting as the Principal Investigator in four of them. The scientific production derived from these projects can be summarized in 50 papers in JCR journals, mostly qualified in the first and second quartile of their expertise area and another 15 publications in technical journals of agriculture and livestock, book chapters and book editions.
Prof. Dr. Jorge Martín-García works as a Professor in Agronomy at the Department of Plant Production and Forest Resources of University of Valladolid, Spain. He has a Phd from the University of Valladolid (Spain) and INRA (France) and has been doubly awarded (Best PhD Awards from Spanish Society of Forest Science and from University of Valladolid). He has also completed three Masters in Bioinformatic and Biostatistic (UOC; 2018), Applied Statistics (UNED; 2013) and Sustainable Use of Natural Resources (UVa; 2006). His research has been carried out in several leading laboratories working on metagenomic, transcriptomic, phytopathology and plant physiology, among other topics. This research was carried out as a postdoctoral researcher at the University of Aveiro (Portugal, Awarded by a FCT fellowship), University of Aberdeen (UK, Awarded by a mobility fellowship) and UVa (Spain, Awarded by an attracting talent fellowship) and as a predoctoral at the LUKE (Finland), INRA (France), University of San Luis (Argentina) and University of Extremadura (Spain). He has lead and participated in more than 30 national and international research projects mainly focused on developing biocontrol or priming strategies based on the use of endophyte fungi. Furthermore, he has been involved in five COST Actions related to fungi, in which he has played a key role, acting as the Grant Holder Manager, Working Group leader or MC member. To date, he has published 58 peer-reviewed articles in JCR journals and several book chapters and is the editor of 3 books. He is an Associate Editor of the Journal of Plant Pathology and Guest Editor for Forests. Beyond the awards received by his PhD, Jorge Martín has also received other awards for his rese
Chapter 1. Endophytic filamentous fungi as sources of metabolites for agricultural applications.- Chapter 2. Yeast as a source of metabolites for agricultural applications.- Chapter 3. Mycorrhizal fungi as a source of metabolites for agricultural applications.- Chapter 4. Fungal metabolites as plant growth promoters in crops.- Chapter 5. Fungal metabolites as inductors of plant abiotic stresses tolerance in crops.- Chapter 6. Fungal metabolites as crop pathogen controllers.- Chapter 7. Fungal metabolites as crop pest controllers.- Chapter 8. Trichoderma as a source of metabolites for applications in agriculture.- Chapter 9. Penicillium genus as a source of metabolites for agricultural applications.- Chapter 10. Aspergillus genus as a prolific source of bioactive metabolites for agricultural applications.- Chapter 11. Fusarium genus as a source of metabolites for agricultural applications.- Chapter 12. Clonostachys genus as a source of metabolites for agricultural applications.- Chapter 13. Fungal Phytopathogens as a source of metabolites for agricultural applications.
| Erscheinungsdatum | 03.02.2025 |
|---|---|
| Reihe/Serie | Fungal Biology |
| Zusatzinfo | VI, 285 p. 27 illus., 12 illus. in color. |
| Verlagsort | Cham |
| Sprache | englisch |
| Maße | 155 x 235 mm |
| Themenwelt | Weitere Fachgebiete ► Land- / Forstwirtschaft / Fischerei |
| Schlagworte | Antibiotics • Antifungals • insecticides • Phytohormones • Trichoderma |
| ISBN-10 | 3-031-76586-9 / 3031765869 |
| ISBN-13 | 978-3-031-76586-5 / 9783031765865 |
| Zustand | Neuware |
| Informationen gemäß Produktsicherheitsverordnung (GPSR) | |
| Haben Sie eine Frage zum Produkt? |
aus dem Bereich


